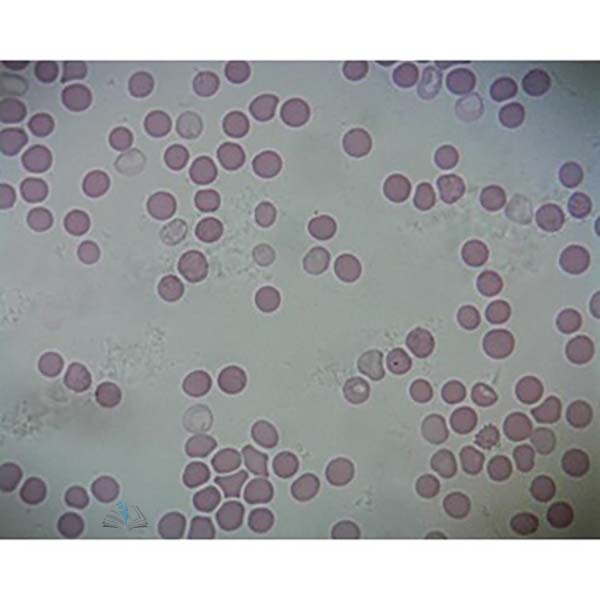
Prepared Microscope Slide - Human Blood Smear

©2026 School Equipments India All Right Reserved
School Equipments India has regular exports of Educational Lab Equipment manufacturer , School Lab Equipment Manufacturer in India , Scienntific Lab Equipment manufacturer in India ,Laboratory Equipment Manufacturer in India , Pharma Lab Instruments , Laboratory Equipment , Analytical Lab Equipment Manufacturers , School lab , Math Lab , Electronics Lab Trainer, Microscopes , Engineering Lab Equipment,Engineering Educational Equipments , Electronic Lab Equipments , Mechanical Engineering Lab Equipment Manufacturer in India,School Lab Equipments Manufacturers ,Educational Lab Equipments Manufacturers, Educational Lab Equipments , Maths Lab Kit Instruments, Physics Lab Instruments,Lab Glassware/a>,Scientific Lab Glassware/a>,Scientific Lab Instruments, Medical Monitoring System and Physiotherapy Equipment for Schools, Colleges, University & Research Labs. Educational Lab Instruments for the following countries: India, Afghanistan, Albania, Algeria, Andorra, Angola, Antigua and Barbuda, Argentina, Armenia, Australia, Austria, Azerbaijan, Bahamas, Bahrain, Bangladesh, Barbados, Belarus, Belgium, Belize, Benin, Bhutan, Bolivia, Bosnia and Herzegovina, Botswana, Brazil, Brunei, Bulgaria, Burkina Faso, Burma/ Myanmar, Burundi, Cambodia, Cameroon, Canada, Cape Verde, Central African Republic, Chad, Chile, Colombia, Comoros, Congo, Congo, Costa Rica, Cote d'Ivoire/Ivory Coast, Croatia, Cuba, Cyprus, Czech Republic, Denmark, Djibouti, Dominica, Dominican Republic, East Timor, Ecuador, Egypt, El Salvador, Equatorial Guinea, Eritrea, Estonia, Ethiopia (Addis Ababa), Fiji, Finland, France, Gabon, Gambia, Georgia, Germany, Ghana, Greece, Grenada, Guatemala, Guinea, Guinea-Bissau, Guyana, Haiti, Honduras, Hungary, Iceland, Indonesia, Iran, Iraq, Ireland, Israel, Italy, Jamaica, Japan, Jordan, Kazakstan, Kenya (Nairobi), Kiribati, Korea, North, Korea, South, Kuwait, Kyrgyzstan, Laos, Latvia, Lebanon, Lesotho, Liberia, Liechtenstein, Lithuania, Luxembourg, Macedonia, Madagascar, Malawi (Lilongwe), Malaysia (Kuala Lumpur), Maldives, Mali, Malta, Marshall Islands, Mauritania, Mauritius, Mexico, Micronesia, Moldova, Monaco, Mongolia, Montenegro, Morocco, Mozambique, Namibia, Nauru, Nepal, Netherlands, New Zealand, Nicaragua, Niger, Nigeria (Abuja), Norway, Oman, Palau, Panama, Papua New Guinea, Paraguay, Peru, Philippines (Manila), Poland, Portugal, Qatar, Romania, Russia, Rwanda (Kigali), Saint Kitts and Nevis, Saint Lucia, Saint Vincent and the Grenadines, Samoa, San Marino, Sao Tome and Principe, Saudi Arabia, Senegal, Serbia, Seychelles, Sierra Leone, Singapore, Slovakia, Slovenia, Solomon Islands, Somalia, South Africa, South Sudan, Spain, Sri Lanka, Sudan, Suriname, Swaziland, Sweden, Switzerland, Syria, Tajikistan, Tanzania, Thailand, Togo, Tonga, Trinidad and Tobago, Tunisia, Turkey, Turkmenistan, Tuvalu, Uganda (Kampala), Ukraine, United Arab Emirates (Dubai), United Kingdom (London), United States, Uruguay, Uzbekistan, Vanuatu, Venezuela, Vietnam, Yemen , Zambia (Lusaka), Zimbabwe

LeafT.S.jpg)

LeafT.S.-PlasticEmbedded.jpg)

XerophyticT.S.jpg)


